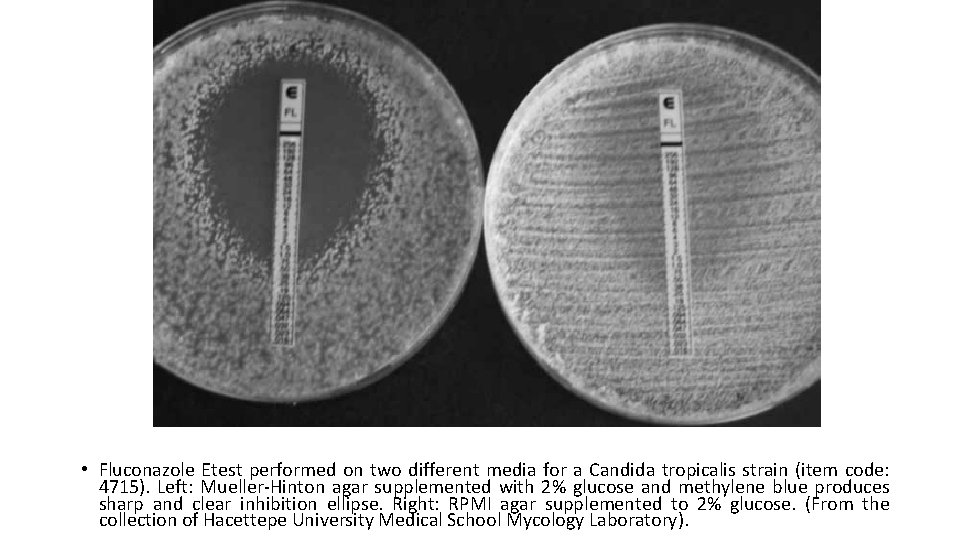
• Fluconazole Etest performed on two different media for a Candida tropicalis strain

Practical medical mycology Lab 9 Antifungal susceptibility test

ﺑﺴﻢ ﺍﻟﻠﻪ ﺍﻟﺮﺣﻤﻦ ﺍﻟﺮﺣﻴﻢ Practical medical mycology Lab 9 Antifungal susceptibility test

History • Antifungal susceptibility testing was not relevant until the introduction in the 1950 s of amphotericin B. • Nearly 30 years after the discovery of the first antibacterial agents, antifungal susceptibility testing lay follow for many years. • While not all fungal infections respond to amphotericin B there were no alternatives. • With the development of Flucytosine and Azole antifungal agents the differences within and between species started to become apparent.

Susceptibility testing • Susceptibility testing of fungi against antifungal drugs commonly used for therapy is a key component of the care of patients with invasive fungal infections. • Antifungal susceptibility testing (AFST) has progressed in recent decades to finally become standardized and available as both Clinical and Laboratory Standards Institute (CLSI) and European Committee on Antimicrobial Susceptibility Testing (EUCAST) reference methods and in commercial manual/automated phenotypic methods.

Why do we need antifungal susceptibility tests? (I) The increase in number of patients with profound immunosuppression and a related increase in incidence and mortality rates of invasive fungal infections that affect these patients (ii) The development and emergence of new antifungal drugs. (iii) The emergence and recognition of antifungal resistance.

The decision to perform an antifungal susceptibility test for a particular clinical fungal strain in routine clinical laboratory practice requires the presence of specified indications. These indications have mostly been documented for yeasts and mostly for Candida. • Invasive infection; Candida strain isolated from a sterile body site • Any Candida species for which high rate of resistance to an antifungal drug or a class antifungal drug is wellknown to be possible (e. g. , C. glabrata-fluconazole and other triazoles) • Unexpected clinical failure during standard therapy of a Candida infection • Surveillance antifungal susceptibility testing to detect/rule out emergence of secondary resistance following prior antifungal therapy

Antifungal susceptibility testing (AFST) results are influenced by methodological factors, including: (I) isolate growth phase and inoculum size; (ii) incubation time and temperature; (iii) media type, particularly relating to glucose concentration; (iv) purity, concentration and activity of the antifungal agent; (v) endpoint stringency for MIC (e. g. 50%, 90%, or 100% growth inhibition); (vi) whether these endpoints are read visually or spectrophotometrically.

• This wide range of variables formed the rationale for developing methodology standards by CLSI and EUCAST. • Each method is time tested, accurate and reliable, but labor-intensive and requires significant training of staff, maintenance of expertise, and a large volume of isolates to be cost effective. • Due to methodological differences, CLSI and EUCAST standard methodologies often yield different MICs and must therefore only be interpreted using the applicable breakpoints.

The major differences in test parameters of CLSI M 27 -A 2 11 and EUCAST E. Dis 7. 1 47 broth dilution methods Test parameter CLSI M 27 -A 2 EUCAST E. Dis 7. 1 Test medium RPMI 1640 with glutamine, without bicarbonate glucose concentration: 0. 2% RPMI 1640 with glutamine, without bicarbonate glucose concentration: 2% Inoculum density 0. 5– 2. 5× 103 cfu/ml 1– 5× 105 cfu/ml Microdilution plates 96 U-shaped wells 96 flat-bottom wells MIC reading time point 48 h 24 h MIC reading method Visual Spectrophotometric (530 nm)

Related CLSI Reference Materials • M 27 reference method for broth dilution antifungal susceptibility testing of yeast. 4 th ed. , 2017. This standard covers antifungal agent selection and preparation; test procedure implementation and interpretation; and quality control requirements for susceptibility testing of yeasts that cause invasive fungal isolates. • M 44 method for antifungal disk diffusion susceptibility testing of yeasts. 2 nd ed. , 2009. tis document provides newly established methodology for disk diffusion testing of Candida spp. , criteria for quality control testing, and interpretive criteria. • M 60 performance standards for antifungal susceptibility testing of yeasts. 1 st ed. , 2017. this document includes updated minimal inhibitory concentrations, zone diameter, and quality control tables for the clinical and laboratory standards institute antifungal susceptibility testing document M 27 and M 44

• The major antimycotic agents can be conveniently divided into true antimicrobials or secondary metabolites isolated from living organisms, and synthetic compounds produced chemically within the laboratory: • Ambruticin, amphotericin B, griseofulvin, nystatin, and pimaricin are examples of natural antimicrobics • clotrimazole, econazole, ketoconazole (R 41, 400), miconazole, 5 -fluorocytosine (5 FC), haloprogen, tolnaftate, and similar compounds are synthetic.

Antifungal susceptibility test principles 1 - broth dilution antifungal susceptibility test. 2 - disk diffusion antifungal susceptibility test. 3 - E-test. 4 - VITEK.

Broth dilution antifungal susceptibility testing for yeasts (CLSI M 27/A 3) • Synthetic media • RPMI 1640 buffered with MOPS( Morpholine propanesulfonic acid) for Candida spp. • Yeast nitrogen broth for Cryptococcus neoformans. • Antifungal agents • Obtained commercially as pure salt. • Amphotericin-B, 5 - Flurocytosine, Azoles such as Fluconazole, Itrracaonazole, Voriconazole, Ketoconazole, Posaconazole, Ravuconazole.

Preparation of stock solution • Water soluble antifungal agent- Fluconazole, 5 -flurocytosine, Caspofungin, Micafungin are prepared in sterile distilled water. • Water insoluble antifungal agent- amphotericin B, itraconaale, posaconazole, ravuconnazloe, and voriconazle are prepared in dimethyl sulfoxide DMSO.

Macro dilution method Procedure Inoculum preparation • All organisms should be sub cultured on to SDA or PDA. • Incubated at 35 C for 24/48 hr. • Inoculum should be prepared by picking five well-isolated colonies of 1 mm in diameter. • Suspend the organisms in 5 ml of sterile saline. • Suspension equal to 0. 5 Mc. Farland standard. • Working suspension is prepared by adding 0. 1 ml of the suspension from above to 9. 9 RPMI.

Test inoculation and incubation • Add 0. 1 ml of each antifungal to a sterile 12 by 75 mm test tube then make serial dilution to each drug with 0. 9 fungal suspension • Growth control tube: 0. 1 ml of drug diluent without the antifungal agent. • Second tube of drug diluent: Un-inoculated to serve as a sterility control. • Within 15 min. of inoculum preparation, 0. 9 ml of the inoculum is added to each tube in the series ( except sterility control) bringing antifungal agents to final concentration. Incubation 35 C for 46 to 50 hr. ( Candida spp. ). • Reading results : amount of growth in each tube is compared to that of the growth control.

Micro dilution modifications • Excellent concordance between results obtained by the broth macro dilution methodology and broth micro dilution adaptation. • Easy to perform, trays may be sealed in plastic bags and stored frozen at -70 C for up to 6 months without deterioration of drug potency. • Stock solutions of antifungal agents and their intermediate concentrations are prepared.


Antifungal disk diffusion susceptibility testing (CLSI M 44/A 2) • Method described is intended for testing candida spp. • Does not encompass any other genera & has not been used in the studies of the yeast form of the dimorphic fungi. • Reagents for the disk diffusion test • Muller Hinton agar+ 2 % glucose+ 0. 5 mcg/ml methylene blue dye medium (GMB); p. H 7. 2 to 7. 4. • 2% glucose provides for suitable fungal growth. • Methylene blue enhances zone edge definition.

Reading plates & interpreting results • Examine each plate after 24 to 24 hr. of incubation. • Measure the zone diameter to the nearest whole millimeter at the point at which there is a prominent reduction in growth.

Interpretative categories • Susceptible (S) : infection due to the strain may be appropriately treated with the dose of antimicrobial agent recommended. • Susceptible dose dependent(S-DD): (Maximal blood levels of the related drug needs to be achieved to treat infections due to S-DD isolates )Includes isolates with antimicrobial agent MICs that approach usually attainable blood& tissue levels but the response rate my be lower than for susceptible isolates( only applies when multiple approved dosage options exist) • Resistant R : isolates are not inhibited by the usually achievable con. of the agent with normal dosage schedules.

CLSI: MIC breakpoints interpretive guidelines for Candida

CLSI: disk diffusion inhibition zone interpretive guidelines for Candida

Methods other than reference assays to detect in vitro antifungal susceptibility

E test ( epsilometer test) • A predefined stable antimicrobial gradient is present on a thin inert non- porous plastic carrier strip 5 mm wide, long known as E- test strip. • Device consists of a predefined, continuous and exponential gradient of antimicrobial con. Immobilized a long rectangular plastic test strip. • Following incubation, a symmetrical inhibition ellipse is produced. • Intersection of the inhibitory zone edge and the calibrated carrier strip indicates the MIC value.

• Following incubation, a symmetrical inhibition ellipse is produced. • Intersection of the inhibitory zone edge and the calibrated carrier strip indicates the MIC value.

• Fluconazole Etest performed on two different media for a Candida tropicalis strain (item code: 4715). Left: Mueller-Hinton agar supplemented with 2% glucose and methylene blue produces sharp and clear inhibition ellipse. Right: RPMI agar supplemented to 2% glucose. (From the collection of Hacettepe University Medical School Mycology Laboratory).

Trailing growth • Azoles, such as fluconazole and itraconazole produce incomplete and partial growth inhibition of Candida. • As a result of this effect, some Candida isolates show reduced but persistent growth over an extended range of the concentrations of the drug in susceptibility testing. • This phenomenon is referred to as ‘trailing’ and results in difficulties in interpretation of visual endpoints in azole susceptibility testing. • Trailing for azoles has mostly been reported for strains of C. albicans and C. tropicalis. • ‘Heavy’ trailers are the most problematic subset of isolates for interpretation of azole susceptibility.

Paradoxical (Eagle) effect • This growth pattern, defined as the paradoxical growth of the fungal strain in vitro at high concentrations that are above the MIC of the drug has so far been observed with echinocandins and itraconazole for Candida. • Decrease in beta-1, 3 - and beta-1, 6 -glucan and a rapid shift of fungal cell wall polymer to chitin has been proposed to be responsible for the paradoxical effect of echinocandins for Candida

Elevated caspofungin concentration phenotypes in two Candida albicans isolates, as evidenced by the Etest agar diffusion test. Numbers on the Etest strip refer to caspofungin concentrations in micrograms per milliliter. The black arrows indicate the MIC. (A) Paradoxical growth; the white arrow indicates the concentration (mg/ml) above the MIC where growth resumes. (B) Trailing effec

Ergosterol quantitation • This novel investigational method is based on measurement of cellular ergo sterol (which is a fungal cell wall target for some antifungal drugs) content rather than the growth inhibition. • For ergosterol quantitation, ergosterol is isolated from whole yeast cells by saponification and the non-saponifiable lipids are extracted with heptane. Ergosterol is finally identified by its spectrophotometric absorbance profile between 240 and 300 nm. • It has particularly been used for testing heavy trailer Candida isolates, which tend to give unclear visual endpoints for fluconazole and/or itraconazole at 48 h.

Time-kill assay • Determination of fungicidal activity by time-kill assay is a valuable tool for attaining information about the dynamic interaction between the fungal strain and the antifungal agent under study. • As would be expected, the assay reveals relative rate and extent of the fungicidal activity and gives information about pharmacodynamic characteristics and post antifungal effect (PAFE) of the agent. The results are analyzed by examining the time-kill plot. • Time-kill kinetics have so far been studied for various antifungal agents against yeasts, including amphotericin B, fluconazole, itraconazole, voriconazole, caspofungin, micafungin, and flucytosine against Candida, and voriconazole and flucytosine against C. neoformans.

Calorimetric method • Based on micro dilution format as CLSI. • Reading end points are enhanced by the use of colorimetric indicator( modified resazurin) • Blue- no growth. • Red- growth. • Purple- partial inhibition.

- Slides: 34